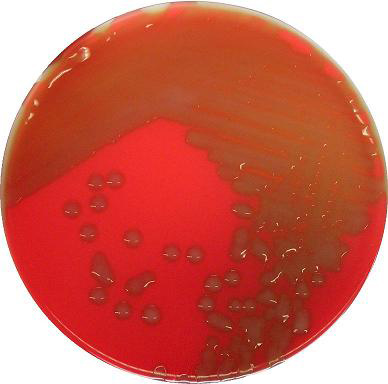
医学检验辅导:溶血葡萄球菌图片

溶血葡萄球菌

孵育24h,图二:二氧化碳环境孵育48h,第三代培养24h后,出现β溶血现象
图片尺寸681x700
溶血葡萄球菌的鉴别要点
图片尺寸587x376
微生物实验考试 葡萄球菌
图片尺寸1080x810
溶血葡萄球菌能根治吗儿童溶血症是怎么回事症状有哪些abo溶血孕前
图片尺寸500x481
今日分享 各种各样的金黄色葡萄球菌,有的溶血环大,有的溶血 - 兑音
图片尺寸1440x2116
各位老师,想问一下痰液中的溶血性葡萄球菌属于致病菌吗? 查看 查看
图片尺寸1944x2592
丹毒是由乙型溶血性链球菌引起的,其次是g,b,c成d组金黄色葡萄球菌
图片尺寸2028x1928
差点漏检的不溶血金黄色葡萄球菌
图片尺寸600x635
医学检验辅导:溶血葡萄球菌图片
图片尺寸388x384
溶血葡萄球菌引起的前列腺炎并不可怕
图片尺寸300x231
差点漏检的不溶血金黄色葡萄球菌
图片尺寸600x604
差点漏检的不溶血金黄色葡萄球菌
图片尺寸600x597
注:制作溶血试验用的血平板,特别是 jin 黄色葡萄球菌的溶血试验,通常
图片尺寸770x682![[向右r]葡萄球菌与无乳比,溶血环更亮,菌落更紧凑,无乳菌菌更稀疏松散](https://i.ecywang.com/upload/1/img2.baidu.com/it/u=3627677905,2882065822&fm=253&fmt=auto&app=138&f=JPEG?w=500&h=500)
[向右r]葡萄球菌与无乳比,溶血环更亮,菌落更紧凑,无乳菌菌更稀疏松散
图片尺寸1080x1080
葡萄球菌
图片尺寸634x443
葡萄球菌
图片尺寸1200x900
金黄色葡萄球菌和化脓链球菌溶血现象
图片尺寸1080x1439
图片浏览
图片尺寸140x120
猩红热(scarlet fever)为a组乙型溶血性链球菌感染引起的急性呼吸道
图片尺寸578x384
口水闻起来很臭,为啥情侣接吻时不觉得恶心?听听科学家的解释
图片尺寸1920x1280